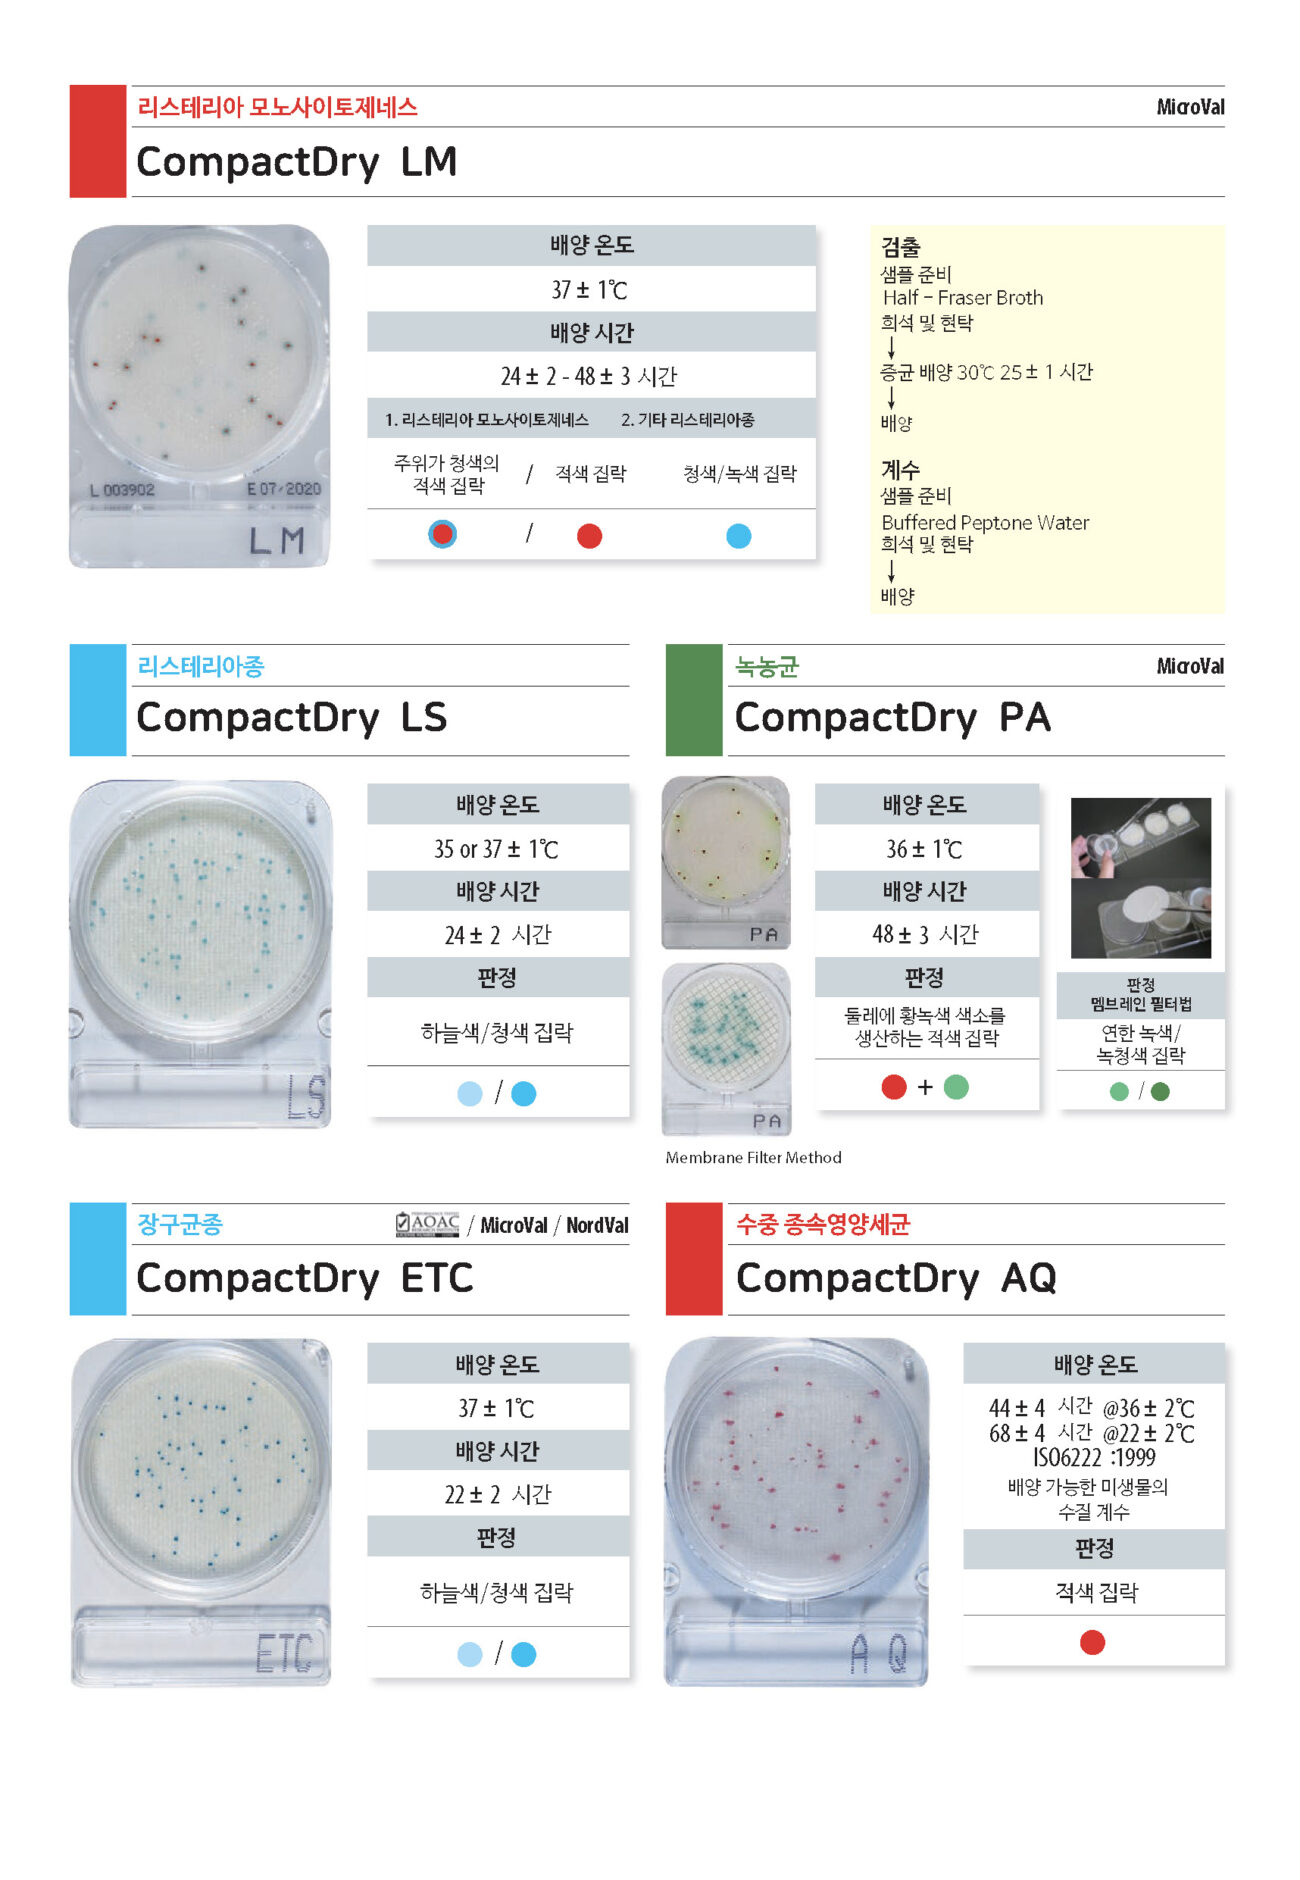

제품개요
식품, 화장품 및 의약품을 포함한 미생물 검사를 간편하고 효율적으로 할 수 있는 미생물 검사용 건조배지
- 실온보관 (1~30도)
- 누름판 필요없이 1ml 분주
- 다양한 균 실험 가능


즉시 사용 가능
- 별도의 멸균 작업 필요없음
- 시간, 물, 에너지 절약가능
- 연속적인 오염 방지
자체 확산 배지
- 단 10초의 간단한 조작으로 사용가능
- 스프레더와 같은 다른 악세사리 필요없음
- 별도의 gelling time이 없으며, 패드에 주입된 배지가 자체 확산되며 응고
- 플레이트를 누르거나, 펴거나, 기울일 필요없음

혁신적인 디자인
- 오염 및 누수를 방지하는 견고한 커버가 있는 컴팩트 플레이트
- 매트한 마감처리로 쉽게 지워지지 않는 메모 작성가능
- 산소의 고른 분포를 위한 공간이 있으며, 손잡이가 있어 쉽게 들 수 있도록 설계됨
- 목표 미생물의 성장을 방해하지 않으면서 인큐베이터의 용량에 따라 무제한 적층 가능
전략적인 패키징
- 실온에서 18-36개월 동안 안정성 유지
- 하나의 샘플 유형을 여러 희석 단계로 그룹화할 수 있는 클러스트 플레이트
- 개별 사용을 위한 플레이트 분리 가능
- 개봉 후 2차 유통기한(30일)에 영향을 받지 않도록 호일에 플레이트 4개씩 개별포장
편리함
- 더욱 간소화된 작업 프로세스
- 균일한 35°C의 배양 온도를 유지 – 효모 곰팡이(25°C) 및 살모넬라(41°C) 제외
- 주입-배양-판독 3단계의 간편한 테스트 과정

폭넓은 측정 항목 및 다양한 응용 분야
- 식품, 의약품 등 미생물 검사 항목 및 기타 특수 항목을 포함하여 총 15가지 항목 측정 가능
- 대부분의 고체 및 액체 샘플, 멤브레인 필터를 사용한 여과, 공중낙하균 등 환경검사 적용 가능
빠르고 정확한 결과값
- 대부분의 항목에 대해 24-48시간 내에 결과 제공
- 확인 디스크나 절차 불필요
- 선명한 색상 대비로 집락 식별 용이
- 공기 공간이 있어 효모와 곰팡이의 3D 성장이 가능하여 구별 용이
- 추가 분석을 위해 분리된 집락을 쉽게 채취 가능
- 국제인증-AOAC, Microval, Nordval
제품종류
| 구분 | 제품명 | 검출시간 | 포장단위 |
|---|---|---|---|
| 일반세균 | CompactDry TC | 48시간 | 40ea/bx |
| 일반세균 (신속형) | CompactDry TCR | 24시간 | 40ea/bx |
| 대장균 & 대장균군 | CompactDry EC | 24시간 | 40ea/bx |
| 대장균군 | CompactDry CF | 24시간 | 40ea/bx |
| 효모 & 곰팡이 | CompactDry YM | 3-7days | 40ea/bx |
| 효모 & 곰팡이 (신속형) | CompactDry YMR | 72시간 | 40ea/bx |
| 황색포도상구균 | CompactDry X-SA | 24시간 | 40ea/bx |
| 장염비브리오 | CompactDry VP | 19시간 | 40ea/bx |
| 바실러스 세리우스 | CompactDry BC | 24시간 | 40ea/bx |
| 살모넬라 | CompactDry SL | 24시간 | 40ea/bx |
| 장내세균과 | CompactDry ETB | 24시간 | 40ea/bx |
| 리스테리아종 | CompactDry LS | 24시간 | 40ea/bx |
| 리스테리아 모노사이토제네스 | CompactDry LM | 24-48시간 | 40ea/bx |
| 장구균종 | CompactDry ETC | 22시간 | 40ea/bx |
| 녹농균 | CompactDry PA | 48시간 | 40ea/bx |
| 수중 종속영양세균 | CompactDry AQ | 44시간 | 40ea/bx |
표를 좌우로 움직이면 전체 내용을 보실 수 있습니다.